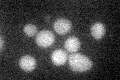
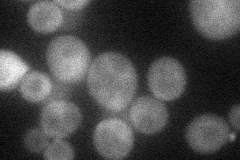
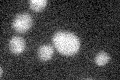

View description
Protein that interacts with silencing proteins at the telomere, involved in transcriptional silencing; has a role in localization of PKA subunit Bcy1p; implicated in mRNA nuclear export; involved in mitotic exit through regulation of Cdc14p
Localization:
Intensity:
Fold change:
Significance:
-
C’ GFP library in SD
cytosol23.31 -
N' NOP1pr-GFP in SD

bud neck43.7814 -
N' TEF2pr-mCherry in SD
bud29.5787 -
N' NATIVEpr-GFP in SD

below threshold24.7896 -
N' TEF2pr-VC and Cyto-VN in SD

cytosol35.466 -
C’ GFP library in SD+DTT

cytosolN/AN/ANo -
C’ GFP library in SD+H2O2

cytosolN/AN/ANo -
C’ GFP library in Starvation Media
cytosolN/AN/AYes -
C’ GFP library on the background of Pup2-DaMP

cytosol -
C’ GFP library on the background of CCT mutant

cytosolN/AN/ANo
